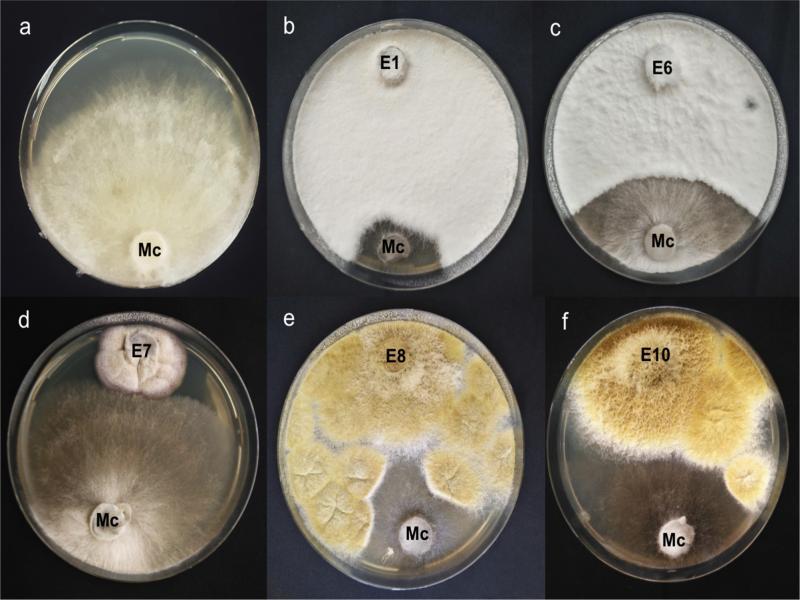
In vitro growth inhibition of Monosporascus cannonballus after dual cultivation with several endophytic fungi from Zataria multiflora.a) M. cannonballus (Mc) alone; b) M. cannonballus + N. sphaerica E1; c) M. cannonballus + N. sphaerica E6; d) M. cannonballus + S. cristata E7; e) M. cannonballus + Paecilomyces sinensis E8; f) M. cannonballus + P. sinensis E10

Fig. 1.
Fig. 2.

Percentage inhibition of mycelial growth of M_ cannonballus by endophytic fungi isolated from Zataria multiflora in dual cultures on PDA_
| Fungal endophyte | % Inhibition |
|---|---|
| Nigrospora sphaerica E1 | 81.7 (64.7) ± 5.5a |
| Nigrospora sphaerica E6 | 66.1 (54.4) ± 1.9a |
| Subramaniula cristata E7 | 38.7 (38.5) ± 3.7b |
| Polycephalomyces sinensis E8 | 80.6 (63.9) ± 11.2a |
| Polycephalomyces sinensis E10 | 75.8 (60.5) ± 9.3a |
Electrolyte leakage induced by culture filtrates of endophytic fungi from the mycelium of M_ cannonballus_
| Treatments | Electrical conductivity (mS cm–1) | ||
|---|---|---|---|
| 0 min | 1 h | 3 h | |
| Nigrospora sphaerica E1 | 3.95 ± 0.02a | 3.98 ± 0.02a | 4.12 ± 0.06a |
| Nigrospora sphaerica E6 | 3.90 ± 0.02b | 3.87 ± 0.02a | 4.01 ± 0.04b |
| Subramaniula cristata E7 | 3.46 ± 0.00c | 3.41 ± 0.01c | 3.55 ± 0.01d |
| Polycephalomyces sinensis E8 | 3.10 ± 0.03d | 3.28 ± 0.14c | 3.14 ± 0.01e |
| Polycephalomyces sinensis E10 | 3.50 ± 0.02c | 3.61 ± 0.00b | 3.71 ± 0.01c |
| Czapek Dox broth (un inoculated) | 2.01 ± 0.00e | 2.01 ± 0.00d | 2.08 ± 0.00f |
| Control (water) | 0.65 ± 0.01f | 0.67 ± 0.00e | 0.71 ± 0.01g |